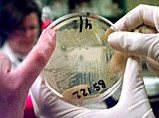
biokemi.jpg (12487 bytes)

USA vil gensplejse en af verdens farligste bakterier til
at blive endnu farligere, for at kunne gardere sig imod brug af den som biologisk våben.
USA mener at biologisk krig ikke er science fiction, men en særdeles nærliggende
mulighed. Derfor vil det nationale sikkerhedsråd sandsynligvis tillade forsøg med
gensplejsning af en af verdens farligste bakterier, miltbrandbakterien. Det skal ske for
at undersøge, hvor farligt et biologisk våben, den kan blive til.
Miltbrandbakterien står i forvejen øverst på listen over
biologiske våben til massiv udryddelse af mennesker over store landområder. Den dræber
på 24 til 36 timer via indånding og blodforgiftning, og hævdes massefremstillet af
blandt andre Irak.
Embedsmænd i det amerikanske forsvarsministerium erkender i New York Times, at USA i
årevis har forsket hemmeligt i udviklingen af nye biologiske våben.
Oplysningerne har straks rejst en storm af protester, fordi internationale aftaler derved
kan være overtrådt. Men embedsmændene forsikrer, at hensigten kun er at komme
fjendtligtsindede magter i forkøbet.
Forskningen skal kun undersøge, hvordan man kan forsvare sig mod nye gensplejsede
organismer og for eksempel lave en vaccine imod dem. Derfor er det nødvendigt også at
skabe dem, mener USA.
Kilde: DR/ritzau
| Nyhedskommentar: Bob bob . . . |
|